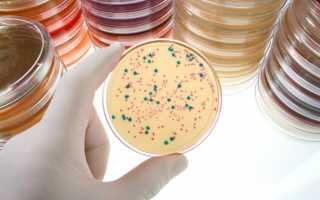

Микрофлора влагалища – это сложная система, которая состоит из множества различных вариантов бактерий. Одни из таких представителей это кокки – целая группа микроорганизмов, которые являются составной частью в норме.
Но при увеличении количества или выявлении специфических видов, следует говорить о патологическом процессе. Поэтому многих кокков относят к условно-патогенной микрофлоры. Для того, чтобы это произошло необходимо воздействие патогенных факторов и некоторых причин.
Микрофлора в норме у женщин
В норме микрофлоры влагалища у женщины представлена различными микроорганизмами, как и любой микробиоценоз. В неё входят представители различных групп. Относительное содержание бактерий меняется в зависимости от возраста и гормонального фона женщины. Представители могут быть как анаэробами, так и аэробными.
Основную долю представителей составляют лактобактрии или палочки Дадерляйна. Они способны вырабатывать молочную кислоту, которая необходима для поддержание достаточных защитных сил в организме.
Относительное количество их доходит до 97%. Остальную группу могут составлять как условно-патогенные, так и патогенные представители. Встречается большое количество стафилококков, кишечной палочки, энтерококков, а так же бифидобактерий. Кроме того это могут быть коринебактерии и др.
Также часто влагалище заселяется транзисторной флорой, которая в норме на длительное время не остаётся.
Большое внимание уделяется тем представителям микрофлоры человека, которые являются аблигатными паразитами.
В некоторый случаях по результатам мазка нет необходимости использовать различные лекарственные средства, так как организм может справиться самостоятельно с нарушенным микробиоценозом. В то же время возбудители инфекций передающихся половым путём требуют обязательного лечения.
Виды кокков
Стрептококки
Это неспецифические микроорганизмы, которые являются представителями нормально микрофлоры женского организма,некоторые виды обладают патогенными свойствами и способны вызывать поражения различный органов и систем.
- Представляет собой кокки различных размеров от мелких до крупных, преимущественно овальной формы.
- Во влагалище женщины может находиться в нескольких видах, основными из которых являются вириданс, группа в и др. Некоторые из видов стрептококков во влагалище женщины могут проявлять лишь патогенные свойства.
- При нормальном количестве не проявляют никаких симптомов, но при увеличении содержания происходит проявление патогенных свойств.
В данном случае это состояние особенно опасно у беременных женщин, так как существует вероятность заражения этими кокками новорожденного в момент прохождения по родовым путям.
Энтерококки
Это широкая группа микроорганизмов, которые относятся к группе кокков.
- Они являются представителями условно – патогенной микрофлоры, поэтому при нормальном состоянии иммунитета не вызывают патологических состояний, но в случае снижения защитных сил, а так же увеличении численного количества происходит проявление патогенных реакций.
- Представляют собой кокки овальной формы, чаще всего располагающиеся цепочками или парами.
- Размеры их достаточно большие. По своим свойствам схожи со стрептококками, длительное время их не выделяли в отдельный вид.
- В норме умеренное количество сосредоточено на слизистых оболочках пищеварительного тракта. Также возбудитель не прихотлив к условиям окружающей среды. Во влагалище может содержаться в небольшом количестве, но при его увеличении происходит проявление патогенных свойств.
Коккобациллы
- Это один из видов микроорганизмов, который входит в состав микрофлоры организма. В данном виде произошло объединение двух представителей микробиоценоза это кокки и бациллы.
- В большинстве случаев данные представители являются патогенной флорой для влагалища.
- Основными из них являются: хламидии, гемофильная палочка и гарнерелла.
- Каждый из них вызывает свое заболевание с присущими только ему характеристиками, при этом если не лечить патологии, то могут возникнуть осложнения.
Если в целом рассматривать данную группу, то благодаря некоторым представителям коккобациллярный флора присутствует всегда во влагалище.
Нормой принято считать отсутствие или единичные представители. Диагноз воспалительного процесса выставляется, если наблюдается обильное содержание флоры.
Рассмотрим основные виды:
- Хламидии – это внутриклеточные микроорганизмы, имеющие округлую форму и очень маленькие размеры. Для организма женщины они являются абсолютным патогеном. Свою устойчивость к воздействию антибиотиков подтверждают труднодоступностью для лекарств, а так же наличием защитных свойств. Они не имеют жгутиков.
- Гарднерелла – это так же представители микробиоценоза, единичные клетки могут быть представлены в организме. Благодаря наличию приспособлений, они крепятся к стенкам слизистой оболочки. Выраженного воспаления они не вызывают, но при этом сильно нарушают состав флоры.
- Гемофильная палочка – это представитель патогенной флоры. Может в единичных количествах содержаться на слизистых ротовой полости, но попадая во влагалище вызывает воспалительный процесс. Во влагалищной флоре в норме жить она не может, так как преимущественно живет в эритроцитах. Является грамотрицательной коккобациллой.
Диплококки
- Диплококки – это одни из представителей кокковой флоры, выделено их достаточно много. Одними из самых опасным являются менингококки.
- В норме во влагалище женщины диплококковый могут присутствовать, они изменение с единичного количества на обилие вызывает в последствии развитие воспалительного процесса или дисбактериоза.
- Представляет собой кокк овальной формы, который находится в паре с другим.
- В процессе своей жизнедеятельности он начинает вырабатывать токсические вещества, которые способны повреждать слизистые оболочки.
- Кроме того, данный вид возбудителя представлен и гонококком, который является патогенным представителем для организма женщины.
Гонококки
Это бактерии, имеющие грамотрицательную структуру.
- Представляют собой образование овальной формы, в некоторых случаях напоминает фасоль или бобы. При этом микроорганизм достаточно распространены среди людей.
- Он не является представителем нормальной микрофлоры влагалища, поэтому при проникновении в слизистую оболочку вызывает воспалительный процесс.
- В окружающей среде проявляет крайнюю неустойчивость, поэтому риск заражения контактно-бытовым путём крайне низкий.
- Чувствителен к действию различных химических и физических факторов, поэтому достаточно легко соблюдать меры профилактике по защите от заболевания. Появиться в мазке они могут уже через несколько дней после заражения, но в среднем это период около недели.
Стафилококки
- Это целая группа микроорганизмов, которая является представителями условно-патогенной флоры организма человека.
- Включает в себя сразу несколько штаммов, каждый из которых обладает определенными качествами.
- Большое число данных возбудителей в норме обитает на поверхности кожи, при этом не вызывает никаких патологических состояний.
- Кроме того, существуют некоторые группы кокков из этого вида, способные вызывать тяжелые заболевания, в том числе и репродуктивных органов у женщины.
- Обладают невыраженной устойчивостью к действию различных средств. Представляет округлое образование, которое в норме располагается в виде гроздьев винограда и сеющих различную форму строения.
- В некоторых случаях их клеточная стенка может быть достаточно толстой и это связано с содержанием большого количества пептидогликана, проявляющего защитные свойства. Передвижение его затруднено из-за отсутствия в строении жгутиков тли ворсинок.
- Благодаря своим факультативно-анаэробным свойствам способны легко расти даже на самых некомфортных условиях проживания. Тяжелые условия переживает в виде L формы.
Количество кокков в мазке
Абсолютного содержания кокков в мазке не производится. Поэтому о патологическом процессе, связанном с кокками в анализах говорит изменение pH среды.
О чем говорит наличие кокков?
Наличие кокков в мазке не всегда сигнализирует о воспалительном или патологическом процессе.
При небольшом количестве кокки будут относить к варианту нормы, лишь при увеличении количественного или качественного соотношения можно говорить о заболевании.Также любое наличие возбудителей, являющихся патологическими, следует относить к патологиям.
Этиология
Причин появления кокков в мазках много. Не всегда нужно думать о попадании микроорганизмов впервые. Многие из них находятся на слизистой оболочке влагалища и в нормальном состоянии.
Поэтому при появлении у женщины симптомов, а также выявлении воспалительного процесса говорят о:
- Снижении иммунных сил,
- Нарушении мер личной гигиены,
- Применении косметических средств с несоответствующими химическим составом.
Специфические возбудители проникают в организм преимущественно после незащищенного полового акта.
В некоторых случаях требуется воздействие провоцирующих факторов. Это неправильное питание, недостаток витаминов, наличие сопутствующих заболеваний, нарушения обмена веществ и эндокринные патологии в анамнезе.
Кокки появляются в мазке и на фоне физиологических процессов изменения микробиоценоза, обычно связанных с гормональным фоном. Это период беременности, пубертата, а также менопаузального перехода.
Симптомы
Проявления кокков в мазке могут быть различными, это связано с тем, что некоторые из бактерий имеют специфические характеристики.
Симптоматика:
- Условно-патогенные микроорганизмы приводят к появлению неспецифического воспаления:
-
В случае выявления специфической инфекции, вызванной кокковой флорой лечение подбирается с учетом чувствительности к патогенному микроорганизму:
- При выявлении гонококков это препараты группы цефалоспоринов: Цефиксим, Ципрофлоксацин, а также группа Офлоксацина. Для уничтожения гонококка достаточно однократного употребления антибиотика в ударной дозе. После проведения терапии требуется контрольный анализ.
- Лечение хламидиоза включает в себя так же прием антибактериальных средств системного действия. Рекомендовано назначать сразу несколько средств в комбинации. К группам средств относят группы тетрациклинов, макролидов, фторхинолонов. Основными из них являются Азитромцин и Джозамицин. Курс составляет в среднем от 7 до 14 дней. Требуется обязательно принимать препараты и половому партнеру, а так же провести контрольное исследование не ранее 2 месяцев. После основного лечения назначается приём пробили ковёр и эубиотиков для восстановления нормального микробиоценоза.
- Лечение бактериального вагиноза в гинекологии, которое вызвано кокком гарднереллой проводится обязательно, так как процесс, возникающий на фоне ее существования, может привести к развитию осложнений. Включает удаление кокков антибактериальными средствами, среди них Метронидазол и Клиндамицин, а также местные формы это крем или свечи с подобным антибиотиком.
- После курса терапии проводят восстановление флоры влагалища. Для этого используются свечи Ацилакт, Лактожиналь и т.д.
Диплококки — разновидность бактерий, имеющих округлый вид, и, как правило, существующих парами. В отдельных случаях, присутствуя в организме, диплококк может быть окружен плотной капсулой.
К диплококкам принято относить следующие виды микроорганизмов: Нейссерии (менингококк, гонококк) и пневмококк (Streptococcus pneumoniae). Иногда во время лабораторного тестирования у женщин диагностируются диплококки в мазке.
Наличие бактерии не свидетельствует о протекающем венерическом заболевании. Но может говорить о других, существующих патологических процессах.
При попадании микроорганизма в урогенитальный тракт могут развиваться разнообразные воспалительные и инфекционные процессы. Если микрофлора влагалища не нарушена, кислотная среда и местный иммунитет в норме, бактерия быстро погибает, не успевая спровоцировать заболевание.
Выявить диплококк можно в нескольких стадиях: внеклеточной (в покое), внутриклеточной (в активной фазе).
В первом случае наблюдаются признаки дисбактериоза влагалища, во втором — симптомы гонорейной инфекции.
- Внеклеточная фаза диплококка
- Причины диагностики диплококков в мазке
- Клинические признаки
- Что делать?
- Диплококки в мазке у мужчин: симптомы
- Методы терапии
- Когда не нужно лечить
- К кому обратиться, если обнаружены?
- Другие заболевания, связанные с диплококками
Внеклеточная фаза диплококка
Для внеклеточной фазы бактериального агента характерно:
- микроорганизм находится в стадии полного покоя, отсутствует рост патогена, его размножение, следовательно, бактерия не провоцирует патологических изменений
- у диплококка в стадии покоя отмечается отсутствие внутриклеточного строения
- нередко выступает в качестве паразитарного микроорганизма
Если обнаружены диплококки в мазке, основные причины явления — нарушение здорового баланса микрофлоры влагалища.
В небольшом количестве диплококки могут присутствовать, не провоцируя развитие патологических нарушений. Но при снижении местного иммунитета и нарушения баланса микрофлоры могут провоцировать ряд негативных изменений. В частности, привести к развитию гонореи.
Причины диагностики диплококков в мазке
Диплококки в мазке могут быть обнаружены по следующим причинам:
- Частое использование антисептических средств для проведения спринцевания влагалища. Как следствие происходит гибель нормальной микрофлоры и замена ее на патогенную.
- Длительное применение бактериостатических препаратов, негативно влияющих на микрофлору кишечника и влагалища.
- Сексуальная активность, начатая в слишком раннем возрасте и частая смена партнеров.
- Половые контакты без использования надлежащих методов контрацепции, некачественная гигиена половых органов.
Клинические признаки
Симптомы, будут достаточно выраженными.
Первое, что можно заметить — изменение выделений из влагалища, появление неприятного запаха. Также зуд, жжение и болезненность при половом контакте. Выделения могут изменять свою консистенцию и цвет, становится более вязкими, приобретать желтый или зеленоватый оттенок.
Диплококки оказывают влияние на работу урогенитального тракта, могут провоцировать симптомы уретрита, цистита, воспаления яичников.
Что делать ?
Что делать, если в мазке появились диплококки?
Присутствие в организме бактерии говорит о текущем воспалительном процессе и необходимости его немедленного лечения. В первую очередь, назначается сдача мазков и ПЦР-анализ для постановки точного диагноза. В данном случае, лабораторное тестирование разрешается в период менструации, при этом, результаты анализов искажены не будут.
Важно! Поставить диагноз «гонорея» можно только при обнаружении внутриклеточного микроорганизм, сдав посев на диплококк.
При выявлении внеклеточной бактерии лечение будет направлено на устранение дисбаланса микрофлоры, а не на терапию венерической патологии.
Возможность развития осложнений при наличии внеклеточного диплококка в мазке не меньше, при выявлении внутриклеточного. Патогенный микроорганизм способен серьезно нарушать микрофлору влагалища.
Он провоцирует воспалительные, инфекционно-гнойные процессы, сопутствует развитию тяжелых форм кандидоза. Независимо от типа микроорганизма потребуется лечение антибиотиками.
После курса бактериостатических препаратов будет назначено лечение с целью восстановления здорового баланса микрофлоры и мочеполовой системы.
Выбор препаратов должен осуществляться квалифицированным врачом. Категорически запрещается заниматься самолечением или заменять один антибиотик другим.
Диплококки в мазке у мужчин: симптомы
Диплококки у мужчин могут проявляться разнообразной симптоматикой, чаще всего следующей:
На 5-7 день после заражения наблюдаются клинические признаки уретрита — воспаление мочеиспускательного канала. Пациент жалуется на жжение, болезненность в момент мочеиспускания, тянущие боли внизу живота. Незначительно повышается температуры тела.
После развития яркой симптоматики наступает некоторое облегчение. Признаки воспаления могут полностью исчезнуть на несколько дней.
Примерно на 14 дней от момента инфицирования клиническая картина возобновляется и дополняется новыми симптомами:
- изменение цвета мочи
- развитие болевого синдрома в пояснице
- появление патологических выделений из уретрального канала с неприятным запахом
При проведении бактериологического посева, как правило, в мазке диагностируют гонококк, подвид диплококка. Может быть поставлен диагноз «гонококковый уретрит» или «гонорея».
Постепенно, в ходе прогрессирования патологического процесса проявляются симптомы пиелонефрита и цистита бактериологической природы.
Методы терапии
Основное лечение инфекции заключается в приеме противобактериальных препаратов. Как правило, назначаются антибиотики широкого спектра действия, с высоким бактериостатическим эффектом.
Назначаемые антибиотики при диплококке в мазке:
- Cefotaximum (Цефотаксим). Антибиотик полусинтетического типа, относится к цефалоспоринам III поколения. Эффективен относительно грамположительных и грамотрицательных бактерий. Выпускается в виде порошка для смешивания со стерильной водой и введения внутримышечно. Вводить препарат необходимо медленно, в течение 3-4 минут. В качество побочных эффектов могут проявиться аллергические реакции в виде кожных высыпаний и нарушения со стороны ЖКТ: тошнота, диарея, боли в животе.
- Ceftriaxone (Цефтриаксон). Цефтриаксон относится к классу лекарств, известных как цефалоспориновые антибиотики, купирует жизнедеятельность бактерий и предотвращает их рост. Препарат назначается для инъекционного введения, обычно один или два раза в день. Из побочных эффектов может возникнуть отек, покраснение или боль в месте инъекции. Также могут наблюдаться нарушения работы желудочно-кишечного тракта: тошнота, рвота, диарея. Цефтриаксон не рекомендуется применять одновременно с препаратами кальция и оральными контрацептивами (антибиотики могут снижать эффективность контрацептивов, рекомендуется использовать дополнительные методы защиты).
- Vancomycin (Ванкомицин). Бактериостатический препарат, продуцируемый Amycolatopsis Orientalis. Перед назначением лекарства проводится диагностика, определяющая чувствительность микрофлоры к данному препарату. Выпускается в виде порошка, для последующего разведения и использования в качестве инъекций. Инъекция Ванкомицина может вызвать побочные эффекты: тошнота, покраснение в месте введения медикамента, незначительное повышение температуры. Не рекомендуется к использованию в период лактации и в первом триместре беременности.
- Dexamethasone (Дексаметазон). В терапии диплококка дополнительным препаратом может стать кортикостероид. Медикамент назначается при развитии неврологических осложнений на фоне инфекционного процесса. Является синтетическим препаратом, полностью имитирующим гормоны надпочечников человека. Выпускается в таблетированной форме и для внутримышечного введения. Противопоказан при острых сердечно-сосудистых нарушениях и психических расстройствах. Также не назначается при язвенном поражении ЖКТ и почечной недостаточности. Из побочных явлений отмечают нарушение работы ЖКТ в виде диареи и тошноты.
При диагностировании гонорейной инфекции, вызванной диплококками, чаще прибегают к назначению Азитромицина. Поскольку в последнее время участились случаи резистентности бактерии к цефалоспоринам.
Классическая доза Азитромицина составляет 0,25 г (одна капсула) один раз в день, в течение двух суток.
В клинических испытаниях большинство сообщаемых побочных эффектов были от легкой до умеренной степени тяжести. Побочные реакции возникают с частотой 1% или менее. Это могут быть следующее симптомы: боль в груди, диспепсия, метеоризм, рвота, вагинит, головокружение, сонливость.
Контрольные анализы после лечения назначаются спустя несколько недель; если диплококки в мазке присутствуют, назначают повторную терапию антибиотиками.
Когда не нужно лечить
Антибактериальная терапия не потребуется, если бактерия является внеклеточной, а также при условии отсутствия симптоматики.
Но, в данном случае будут рекомендованы препарата на основе Lactobacillus и Bifidobacterium для нормализации влагалищной микрофлоры.
К кому обратиться, если обнаружены?
Лечением занимается врач-венеролог. Также можно обратиться к урологу или гинекологу.
Какова основная профилактика, позволяющая снизить к минимуму риски обнаружения диплококка в мазке?
Минимизировать беспорядочные половые контакты, тщательно следить за гигиеной половых органов и своевременно проводить лечение инфекционных патологий.
Другие заболевания, связанные с диплококками
Neisseria meningitidis (менингококк)
Neisseria meningitidis — это грамотрицательная бактерия, которая колонизирует носоглотку человека. Она имеет 13 серотипов и является основной причиной бактериального менингита и сепсиса (заражение крови).
Патогенность бактерии заключается в том, что капсула, которой окружена нейссерия, сопротивляется фагоцитозу человеческого тела.
Заставляет ее размножаться в организме, вызывая инфекционные процессы. В основном вызывает воспаление лобных пазух, бронхит, плеврит, сепсис и т. д.
Менингококк обычно заражает детей и подростков с ослабленным иммунитетом. Как правило, болезнь начинается через день-два после проникновения патогена в организм.
Бактерия локализуется в верхних дыхательных путях, не вызывая никаких симптомов. Основной путь передачи – воздушно-капельный.
Существует несколько видов менингококковой инфекции, диагностируемых в 90% случаев.
Оба заболевания потенциально опасны для жизни:
Самый известный тип менингококковой инфекции. Бактерии атакуют мозговые оболочки, вызывая их воспаление.
Болезнь проявляется неврологическими симптомами. Такими как острая головная боль, скованность в шее и неспособность согнуть голову вперед. Данные симптомы сопровождаются лихорадкой, тошнотой и рвотой.
Летальный исход от инфекции диагностируется только в 10% случаев. В некоторых случаях менингококк может провоцировать суставные инфекции и воспаление миокарда.
Большинство менингококковых инфекций встречаются в более теплых районах, в основном зимой и весной.
- Менингококковый сепсис
Менингококковый сепсис является чрезвычайно тяжелым заболеванием с уровнем смертности около 25%. Термин сепсис («отравление крови») означает распространение бактерий по всему телу через кровеносную систему. Meningococcus способен вызвать наиболее тяжелое септическое состояние из-за обильно продуцируемого вещества, называемого липополисахаридом.
Вещество выделяется в больших количествах в кровь. Вызывает сильный иммунный ответ на фоне чрезмерного продуцирования патогенов. Как следствие, наблюдается острое нарушение кровообращения.
Организм пытается предотвратить распространение инфекционного агента. Но вместе с тем не нарушить работу сердца, головного мозга и надпочечников.
Как следствие, другие органы страдают от дефицита кислорода и питательных веществ. Наблюдается острое нарушение их функционирования. В первую очередь, страдает печень и почки.
Менингококковый сепсис сопровождается понижением артериального давления, увеличением сердечного ритма, частоты дыхания, бледностью и нарушением мочеиспускания.
Тяжелая инфекция может привести к опасной гипотензии (шоку), склонности к кровотечениям и дисфункции нескольких органов ((например, печени и почек) (отказ)). От 10 до 15% пациентов с менингитом умирают даже после лечения.
Среди выздоравливающих людей 10-20% будут иметь серьезные осложнения. Такие как постоянная глухота, умственная отсталость, в тяжелых случаях может потребоваться ампутация пальцев ног, рук. Нередко инфекция протекает медленно и вызывает умеренно прогрессирующие симптомы, к примеру, незначительное повышение температуры тела.
Основное лечение: внутривенные антибиотики (обычно пенициллин) и внутривенная регидратация (восстановление водного баланса). Может потребоваться использование кортикостероидов.
Гонококк (Neisseria gonorrhoeae)
Neisseria gonorrhoeae является одной из наиболее распространенных инфекций, передаваемых половым путем (ИППП). Это исключительно человеческий патоген, который уклоняется от иммунной системы хозяина посредством множества механизмов.
N. gonorrhoeae подавляет способность антигенпредставляющих клеток индуцировать пролиферацию CD4 Т-клеток.
Гонококк имеет вид неподвижного парного кокка, половинки которого визуально напоминают кофейное зерно. При развитии неблагоприятных условий (воздействие бактериостатическими препаратами), бактерия трансформируется и изменяет собственные свойства. Гонококк отличается повышенной устойчивостью в организме человека, но во внешней среде быстро погибает.
Neisseria gonorrhoeae передается путем сексуального контакта, где не были использованы защитные методы контрацепции. У некоторых пациентов заболевание протекает в бессимптомной форме, данное явление чаще встречается у женщин.
Основная локализация гонококков и их паразитирование наблюдается на слизистой уретрального канала, шейки матки, нижней части прямой кишки, конъюнктивы. Инфекция склонна протекать совместно с другими типами ЗППП.
Часто при наличии гонореи диагностируется хламидиоз, сифилис, трихомониаз. Терапия инфекционного процесса заключается в использовании антибактериальных препаратов. Наиболее эффективными считаются средства цефалоспоринового ряда.
Пневмококк (Streptococcus pneumoniae)
Пневмококки представляют собой грамположительные бактерии рода Streptococcus. Принадлежат к семейству Lactobacillales и окружены полисахаридной капсулой. Структура капсулярных полисахаридов имеет решающее значение для серотипа и антигенности. Капсула также отвечает за патогенность возбудителя и защищает его от фагоцитоза.
Антитела против патогена обычно появляются через 5-8 дней после заражения и направлены против капсулярных полисахаридов. Тем не менее, иммунный ответ зависит от В-клеток. Это объясняет, почему дети не развивают специфический для серотипов иммунитет в первые два года жизни. Поэтому подвергаются особому риску.
Морфологически пневмококки являются диплококками, поскольку бактерии расположены парами.
Пневмококк является одной из наиболее распространенных бактериальных причин пневмонии. Бактерии обычно инфицируют дыхательные пути, которые ранее были ослаблены местной вирусной инфекцией. Симптомы включают высокую температуру тела, кашель с отхаркиванием слизи и гноя, боль в груди и одышку.
Pneumococcus может распространяться на миндалины и вызывать классический тонзиллит. Болезнь сопровождается высокой температурой, недомоганием и выраженной болью в горле. Боль обычно усиливается при глотании, миндалины увеличены, красные и покрыты беловатым налетом.
Пневмококк является распространенной причиной инфекции среднего уха. Заболевание проявляется сильной болью в ухе, лихорадкой, недомоганием и иногда снижение слуха.
В качестве заболевания особенно опасен менингит. При этом пневмококки после менингококков представляют собой вторую по распространенности причину бактериального менингита. Заболевание часто встречается у детей в результате инфекции верхних дыхательных путей.
Симптомы зависят от возраста детей. Пневмококковая болезнь лечится антибиотиками, такими как цефалоспорины.
При выявлении диплококков в мазке обращайтесь к автору этой статьи – венерологу в Москве с многолетним опытом работы.
Диплококки в мазке у женщин, что это
Диплококки – это обозначение целой группы микроорганизмов. Они отличаются тем, что располагаются парами и имеют оболочку. Могут существовать в клетке и во внеклеточном пространстве:
- Внеклеточные диплококки не слишком опасны. Обнаружение их в мазке не говорит о патологии. Такие бактерии легко разрушаются под влиянием антисептиков и кислой среды, которая присутствует во влагалище здоровой женщины.
- Внутриклеточные диплококки проникают в ткани организма, вызывая опасные заболевания.
Также различают грамотрицательные и грамположительные бактерии. К первому типу относятся микроорганизмы с тонкой оболочкой и высокой устойчивостью к антибиотикам. Грамположительные диплококки легче подавляются лактобактериями во влагалище, восприимчивы к воздействию антисептиков и антибактериальных препаратов. Они обнаруживаются на слизистой здоровых людей, и способны причинить вред при активном размножении из-за снижения иммунитета или нарушения микрофлоры.
Причины обнаружения диплококков в мазке
Некоторые виды микроорганизмов, например, стрептококки, стафилококки и гарднерелла являются частью нормальной микрофлоры. Они, наряду с лактобактериями, заселяют слизистую оболочку влагалища. Здоровой женщине они не причиняют дискомфорта. Рост колоний условно-патогенных микроорганизмов приводит к дисбиозу. Происходит это преимущественно из-за снижения местного и общего иммунитета, пренебрежения правилами личной гигиены.
Нередко в мазке обнаруживаются гонококки. Это возбудители гонореи. Они передаются половым путем и способны поразить все органы мочеполовой системы.
Симптомы отклонений от нормы
Небольшое количество диплококков не вызывает неприятных ощущений. Начальные стадии дисбиоза характеризуются необычными жидкими выделениями белого или серого цвета. Иногда появляется запах несвежей рыбы. С развитием патологии слизь из влагалища становится более густой, приобретает желтоватый оттенок. Выраженный дисбиоз сопровождается зудом и жжением. Без лечения процесс может перейти в тяжелое воспаление влагалища и шейки матки. В этом случае симптомы будут зависеть от возбудителя.
Признаки гонококковой инфекции зависят от формы заболевания.
Острая стадия характеризуется:
- жжением и зудом во влагалище и уретре;
- покраснением и отечностью слизистых;
- появлением гнойных выделений;
- у входа во влагалище в месте соединения половых губ может образоваться болезненное уплотнение;
- паховые лимфатические узлы воспаляются.
Хроническая гонорея имеет вялотекущее развитие. Симптомы смазаны. Примерно у половины заболевших признаки отсутствуют при обеих формах патологии.
Диагностика
При обнаружении диплококков в мазке необходим микроскопический анализ с использованием красящего вещества, чтобы определить грамположительные это бактерии или нет. Также назначают ПЦР-исследование, которое помогает точно установить возбудителя. Дополнительно проводят бакпосев и определяют чувствительность микроорганизмов к антибиотикам.
Лечение
Грамположительные диплококки обычно не требуют проведения лечебных мероприятий. У здоровой женщины они подавляются лактобактериями и не вызывают дискомфорта. При возникновении дисбиоза требуется повышение иммунитета и восстановление баланса микроорганизмов. Как правило, в этом случае прописывают общеукрепляющие средства и пробиотики.
Серьезные воспалительные процессы купируются антибиотиками, а также антисептическими и противовоспалительными средствами. Подбирать лечение самостоятельно нельзя. Необходимо сначала определить чувствительность возбудителя к антибиотикам. Если препарат окажется неподходящим, колонии патогенов продолжат размножаться, а остатки полезной микрофлоры погибнут. Это приведет к хронизации процесса и тяжелым осложнениям вплоть до воспаления матки и бесплодия.
При обнаружении диплококков в мазке не стоит впадать в панику. Не всегда эти микроорганизмы вызывают заболевания. Даже если патология есть, на начальных стадиях от нее легко избавиться. Главное, правильно подобрать лечение и соблюдать все рекомендации врача.



 Это неспецифические микроорганизмы, которые являются представителями нормально микрофлоры женского организма,некоторые виды обладают патогенными свойствами и способны вызывать поражения различный органов и систем.
Это неспецифические микроорганизмы, которые являются представителями нормально микрофлоры женского организма,некоторые виды обладают патогенными свойствами и способны вызывать поражения различный органов и систем.